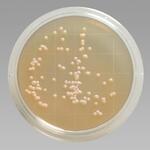
Thermo scientific Remel kontaktlemez steril triptikus szója agar lecitinnel, poliszorbát 80 (besugárzott) product image

Thermo scientific ültetőlemez, steril, triptikus szója-agar (besugárzott), Mikrobiológiai táptalaj
Termék tulajdonságai
- Talaj típusa: szilárd
Termék leírása
A Thermo Scientific Remel Steril Triptic Soy Agar (besugárzott) ülepítőlemez segítségével sokféle organizmus izolálása és tenyésztése, például baktériumok, élesztőgombák és gombák. A víz és szennyvíz vizsgálatának szabványos módszerei és az élelmiszerek mikrobiológiai vizsgálati módszereinek gyűjteménye 1,2 . Használata javasolt az AOAC International, a Nemzetközi Tejipari Szövetség (IDF) és az...
Tovább
TS Labor Kft. további termékei
Tenyészthet és izolálhat igényes kórokozókat és más mikroorganizmusokat a Thermo Scientific Oxoid Nutrient Agar (dehidratált) segítségével. Ez a nem szelektív tápközeg marhahús kivonatokat tartalmaz...
tovább
Határozza meg a mikroorganizmusok lemezszámát élelmiszerekben, tejmintákban, szennyvízben és egyéb egészségügyi szempontból fontos anyagokban a Thermo Scientific Oxoid lemezszámító agarral...
tovább
A Gibco Terrific Broth egy használatra kész folyékony táptalaj, amelyet baktériumtenyésztéshez használnak. A szűrővel sterilizált Gibco Terrific Broth termékünk szinte minden olyan kutatási...
tovább
Az LB Broth (1X) egy használatra kész folyékony táptalaj, amelyet baktériumtenyésztéshez használnak. Szűrővel sterilizált LB-levesünk szinte minden olyan alkalmazáshoz használható, amely folyékony...
tovább
A Thermo Scientific Remel kontaktlemez steril triptikus szójaagar lecitinnel, poliszorbát 80-zal (besugárzott) baktériumok, élesztőgombák és gombák tenyésztésére szolgál. Dupla zacskós plusz egy...
tovább
Utolsó frissítés dátuma:
2026-03-10 02:12 *
A termék forgalmazója
75%
válaszarány
4 nap
válaszidő
5.0
Válaszarány:
A beérkezett ajánlatkérések hány százalékára válaszolt a cég.
Válaszidő:
Ez a szám azt mutatja, hogy átlagosan mennyi idő alatt válaszoltál az ajánlatkérésekre. Az átlagba csak a megválaszolt ajánlatkérések számítanak bele.
(A statisztikák az elmúlt 180 nap adatai alapján készülnek.)
Értékelés:
A cég kiadott ajánlatait, az ajánlatkérők így értékelték.
zöld jelzőlámpás cég

Ez a cég a bisnode által zöld minősítést kapott.
Árbevétel
1 325 591 000 (Ft)
Adózott eredmény
38 468 000 (Ft)
Jegyzett tőke
6 000 000 (Ft)
Adószám
12279144-2-41
Alapítás
1997
Cég státusza
Működő
Negatív esemény
Nincs
Székhely
További telephelyek